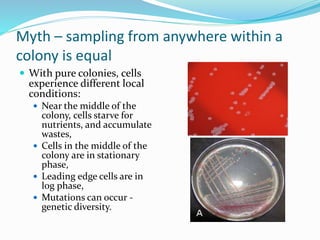
Myth – sampling from anywhere within a
colony is equal
 With pure colonies, cells
experience different local
conditions:
 Near the middle of the
colony, cells starve for
nutrients, and accumulate
wastes,
 Cells in the middle of the
colony are in stationary
phase,
 Leading edge cells are in
log phase,
 Mutations can occur -
genetic diversity.

The document discusses prevalent myths in microbiology, particularly regarding colony-forming units, the effectiveness of laboratory cabinets, media growth promotion, microbial distribution in cleanrooms, and environmental monitoring parameters. It emphasizes the complexities and inaccuracies surrounding microbial detection and categorization, including misconceptions about aseptic techniques and the significance of thorough testing. The document advocates for a more nuanced understanding of microbial behavior and the limitations of traditional diagnostic methods.